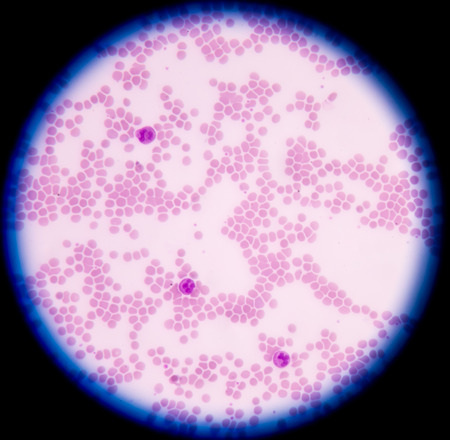
White blood cells of a human, photomicrograph panorama as seen under the microscopeの写真素材

写真素材 - White blood cells of a human, photomicrograph panorama as seen under the microscope
作品情報
White blood cells of a human, photomicrograph panorama as seen under the microscope
- ID:40857539
- 作品種別:写真
- 作者名:toeytoey
キーワード
- abnormal
- acute
- anemia
- antigen
- bactericidal
- basophil
- beta
- biology
- blast
- blood
- bone
- cell
- cytoplasm
- decrease
- disease
- eosinophil
- granulation
- health
- hematology
- immune
- infection
- laboratory
- leukemia
- leukocyte
- lobed
- lymphocyte
- macrocyte
- marrow
- medical
- medicine
- microbiology
- microcyte
- microscope
- monocyte
- neutrophil
- normal
- nucleus
- organism
- pathology
- phagocytes
- platelet
- pmn
- response
- segmented
- slide
- smear
- system
- thalassemia
- thalassemias
- toxic
- white
- metamyelocyte
類似作品
Red blood cells...
Red blood cells...
Red blood cell ...
Red blood cells...
Delicious glaze...
Red blood cells...
Floating in a d...
Red blood cells...
Abnormal red bl...
Polycythemia ve...
Blood Cells bac...
Red blood cells...
3d render of bl...
Blood cells. me...
3d illustration...
Deadly Virus 3D...
Close-up of a s...
3D illustration...
Red blood cell ...
White blood cel...
blood 3D Render...
Red blood cells...
blood cell for ...
Red blood cells...
Bacteria cells ...
Red blood cells...
Picture of acut...
Red blood cells...
Colorful drops ...
Healthy human r...
White blood cel...
red blood cells
Babesia parasit...
white blood cel...
Red blood cells...
Red blood cells...
Red and white b...
Healthy human r...
Red blood cells...
Closeup shot of...
Red blood cells...
plasmodium falc...
Cancer cells.3d...
symbolic virus ...
Normal red bloo...
3d rendering re...
Red and white b...
Red and white b...
Red bubbles of ...